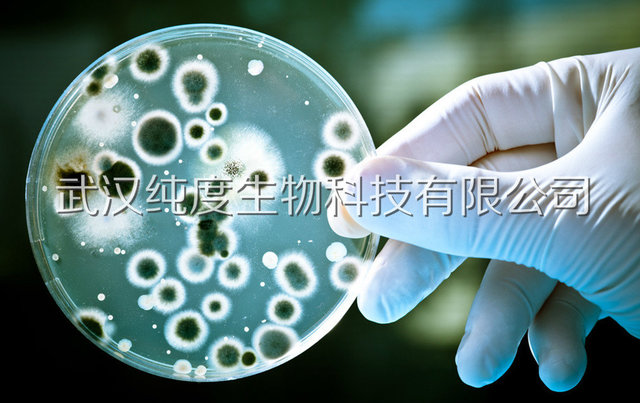
BIGGY 琼脂BIGGY agar

相关产品推荐更多 >
万千商家帮你免费找货
0 人在求购买到急需产品
- 详细信息
- 技术资料
- 库存:
货物充足
- 供应商:
武汉纯度生物科技有限公司
- 英文名:
BIGGY 琼脂BIGGY agar
- 规格:
250g
产品用途:用于细胞培养
产品性状:请联系客服人员
储存条件:详情参考说明书
联系电话:15527510518 18163548455 13296670271 13296673586
QQ:1546342329 3176445674
武汉纯度生物科技有限公司,主要销售常用抗原抗体、试剂、Elisa试剂盒、生化试剂盒、免疫检测试剂盒、金标试剂盒、金标检测卡、动物血清、血浆、全血、抗血清、毒素类标准品、生物试剂、培养基、实验室仪器耗材、化学试剂、生物制品、标准品、对照品、生化免疫制品、免疫亲和柱、菌株、质粒、室内质控品、细胞、培养基、PEG、病理染色液、免疫学试剂、蛋白组学试剂、细胞生物学试剂、分子生物学试剂、抑制剂、细胞因子等。武汉纯度生物时刻谨记产品质量,正如公司名一样,达到“专业规格,纯度保证”的质量生命线。公司秉承“客户为天,质量为根,诚信为本,创新为魂”的信念,将以优质的产品,完善的服务,为每一位客户的实验保驾护航。
ELISA酶联免疫试剂盒有(牛、马、山羊、绵羊、人、狗、兔、鸡、豚鼠、猪、植物、猴子、大鼠、小鼠、鱼,虾蟹,菌类等)种属相关试剂盒,食品安全类检测试剂盒(黄曲霉毒素B1 elisa检测试剂盒、呕吐毒素elisa检测试剂盒、桔青霉素elisa检测试剂盒等)农药残留检测试剂盒厂家直销、指标齐全、种类齐全、可提供免费代测、提供技术支持、品质可靠、价格优势,欢迎咨询合作。
生化试剂盒(植物激素类、土壤类、谷胱甘肽类、蛋白酶类、蔗糖、淀粉类试剂盒、氨基酸代谢类、脂酶类)分光光度法试剂盒,微量法试剂盒、气相试剂盒,液相试剂盒、DNA提取试剂盒等、乳胶增强免疫比浊法、双缩脲等方法试剂盒,乙肝甲肝梅毒等胶体快速检测卡、试剂条。

血液制品:各种动物血清(人血清、新生牛血清、标准马血清、特级马血清、山羊血清、绵羊血清、兔血清、鸡血清、大牛血清、小牛血清、猪血清、狗血清、猫血清、鱼血清、驴血清、豚鼠血清、大鼠血清、小鼠血清、SD鼠血清、巴比西鼠血清)满足各种实验需求。
动物血浆:人血浆、新生牛血浆、大牛血浆、小牛血浆、绵羊血浆、山羊血浆、猪浆、驴血浆、马血浆、狗血浆、大鼠血浆、小鼠血浆、豚鼠血浆、兔血浆、空白小鼠血浆、空白大鼠血浆、SD大鼠血浆等等。
动物红细胞:绵羊红细胞、兔血红细胞、鸡血红细胞、豚鼠血红细胞等、SPF级鸡红细胞、(1%2%3%4%6%10%20%)浓度可定做。
抗凝脱纤维抗凝血:人血、猪血、羊血、鸡血、鸭血、马血、驴血、牛血、狗血、猫血等,均为无菌包装,保质期一个月,血源可靠,品质保障,抗凝剂(柠檬酸钠/肝素钠/EDTA k2/草酸钾/阿氏液)均可定制。
毒素标准品、:N-二乙基亚硝胺(标准品/试剂)环氧化苯并芘(规格齐全)Aflatoxin B1黄曲霉毒素B1标准品(以色列原装进口,带证书,纯度99.8%)、Aflatoxin B2黄曲霉毒素B2、Aflatoxin G1黄曲霉毒素G1、Aflatoxin G2黄曲霉毒素G2、Aflatoxin M1黄曲霉毒素M1、Aflatoxin M2黄曲霉毒素M2、Deoxynivalenol脱氧雪腐镰刀菌烯醇(DON)、3-Acetyl-Deoxynivalenol3-乙酰基脱氧雪腐镰刀菌烯醇(3-A-DON)、15-Acetyl-Deoxynivalenol 15-乙酰基脱氧雪腐镰刀菌烯醇(15-A-DON)、Nivalenol雪腐镰刀菌烯醇(NIV)、Fumonisin B1 伏马毒素B1、Fumonisin B2 伏马毒素B2、Ochratoxin A 赭曲霉毒素A、Zearalenone玉米赤霉烯酮、T2 Toxin T-2 毒素、Citrinin桔青霉素/桔霉素、Patulin棒曲霉素/展青霉素标准品、Sterigmatocystin杂色曲霉素等,药物标准品,中检所标准品,详情咨询客服!
食品安全农药残留抗原抗体等实验室常用于胶体金、ELISA、免疫等体外免疫诊断原料:地塞米松抗原抗体、喹乙醇抗原抗体、红霉素抗原抗体、黄曲霉毒素B1单克隆抗体、青霉素结合蛋白、红霉素-BSA抗原抗体、孔雀石绿抗原抗体、三聚氰胺(MEL)单抗、三聚氰胺单克隆抗体、雌三醇的抗原抗体原料、赭曲霉毒素抗原抗体、黄曲霉毒素M1抗原抗体、莱克多巴胺偶联抗原、微囊藻毒素抗原抗体、地塞米松抗原抗体、雌二醇(E2)抗原抗体、呕吐毒素单克隆抗体、伏马毒素单克隆抗体等,可用于用于IVD的研发,满足各种实验
动物疫病类抗原抗体:抗猪传染性胃肠炎病毒(TGEV)单克隆抗体、抗弓型虫(Toxo)单克隆抗体、、抗轮状病毒单克隆抗体、抗沙门氏菌单克隆抗体、抗鼠伤寒沙门氏菌单克隆抗体、抗牛冠状病毒单克隆抗体、抗牛布鲁氏菌单克隆抗体、抗传染性支气管炎病毒(IBV)单克隆抗体、抗传染性法氏囊病毒(IBDV)单克隆抗体、抗甲型流感H5亚型单克隆抗体、抗甲型流感H7单克隆抗体、抗狂犬病毒(RV)单克隆抗体、抗狂犬病毒N蛋白单克隆抗体、抗犬瘟热单克隆抗体、抗犬细小单克隆抗体、抗猪流行性腹泻单克隆抗体、小反刍兽疫N蛋白单克隆抗体、抗弓形虫单抗(Toxo)、抗猪圆环病毒抗原抗体、猪蓝耳病毒抗原抗体、猪口蹄疫病毒蛋白抗体、猪伪狂犬病毒重组蛋白等。
常用诊断试剂用原料抗原-抗体(肿瘤标志物类、传染病类、心肌标志物类、优生及不孕不育类、生化免疫类原料、免疫球蛋白类、肝肾功能疾病类、激素、胰岛素类)蛋白质、多肽

公司销售单克隆抗体、多克隆抗体、标记类抗原抗体、免疫血清、抗血清、酶标记二抗IgG,荧光标记二抗IgG,阳性阴性参考血清(鸡抗HBsAg、驴抗羊IgG、驴抗兔IgG、驴抗HBsAg、豚鼠抗HBsAg、豚鼠抗羊IgG、豚鼠抗驴IgG-IgG、豚鼠抗人IgG、羊抗鼠IgG、羊抗鼠IgA、羊抗鼠IgM、羊抗鼠IgG3、羊抗鼠IgG2b、羊抗兔IgG、羊抗人IgG、兔抗鼠IgG、兔抗人IgG、兔抗鸡IgY、兔抗鸡IgY、兔抗大鼠IgG、兔抗羊IgG、兔抗人-IgG、人IGG、抗人a1AT血清、兔抗人全血清、羊抗马IgG血清、羊抗牛IgG血清、羊抗狗IgG血清、羊抗猪IgG血清、羊抗猫IgG血清、兔抗人IgA血清、兔抗人IgM血清、羊抗人IgG荧光抗体、羊抗兔IgG荧光抗体、兔抗绵羊红细胞(溶血素)、冻干抗人IgA血清、冻干羊抗人IgM血清、冻干羊抗人C3血清、冻干羊抗人C4血清、冻干羊抗人C3C血清、HRP标记羊抗人IgM、HRP标记羊抗人IgA、HRP标记羊抗人IgG+IgM+IgA、HRP标记羊抗人白蛋白、HRP标记羊抗HBsAg、HRP标记羊抗HBsAg-ALP标记、HRP标记羊抗人PSA、HRP标记羊抗人CEA、HRP标记羊抗人AFP、HRP标记羊抗人CA125、HRP标记羊抗铁蛋白IgG、HRP标记羊抗人CA199、HRP标记羊抗人血红蛋白、HRP标记羊抗人前白蛋白、HRP标记羊抗人载脂蛋白A1、HRP标记羊抗人载脂蛋白B、HRP标记羊抗人急性反应蛋白)等。
公司销售免疫组化常用试剂、细胞生物学试剂、分子生物学试剂、亲和层析柱、分子试剂盒,缓冲液染色液蛋白质Marker,细胞,多肽,培养基,产品保证质量,售后稳定,规格齐全尽在武汉纯度生物。
实验材料太多无法一一介绍,公司能为生命科学领域的广大科研人员提供数万种抗体、数千种蛋白以及相关检测试剂盒等。公司产品数量充足,试剂盒类目,抗原抗体等材料多达上万种,其他生物实验试剂耗材备货充足,可随时为广大科研人员提供所需产品。具体产品请联系销售人员,支持淘宝订货。
公司可提供正规发票!
热线电话:15527510518
公司电话:027-65382163
QQ:1546342329/3176445674
企业支付宝:1546342329@qq.com
对公账户:武汉纯度生物科技有限公司127910161310301
开户银行:招商银行武汉光谷支行
平板计数琼脂(PCA)颗粒 Plate Count Agar 国际标准平板计数琼脂,含糖,用于细菌总数的测定
营养肉汤(NB)颗粒 Nutrient Broth 一般细菌培养、转种、复壮、增菌
营养琼脂(NA)颗粒 Nutrient Agar 细菌计数、不含糖,可作血琼脂基础和传代用
月桂基硫酸盐胰蛋白胨肉汤(LST)颗粒 Lauryl Sulfate Tryptose Broth 用于大肠菌群,大肠埃希氏菌的测定
煌绿乳糖胆盐肉汤(BGLB) 颗粒 Brilliant Green Lactose Bile Broth 用于大肠菌群,大肠埃希氏菌的测定
乳糖胆盐发酵培养基颗粒 Brilliant Green Lactose Bile Broth 用于大肠菌群,粪大肠菌群,大肠埃希氏菌的测定
结晶紫中性红胆盐琼脂(VRBA)颗粒 Violet Red Bile Agar 用于大肠菌群的固体平板检测
乳糖蛋白胨培养液 颗粒 Lactose Peptone Broth 用于饮用水,水源水中总大肠菌群的测定
麦康凯琼脂 颗粒 MacConkey Agar Medium 用于肠道致病菌的选择性分离培养
麦康凯肉汤 颗粒 MacConkey Broth Medium 用于肠道致病菌的增菌培养
EC 肉汤 颗粒 E.Coli Broth 用于粪大肠菌群、大肠埃希氏菌的测定
液体硫乙醇酸盐培养基颗粒 Thioglycollate Medium 用于药品,生物制品无菌试验,用于需氧菌、厌氧菌的培养
改良马丁培养基 颗粒 Martin Medium, Modified 用于药品及生物制品霉菌无菌检验
改良马丁琼脂培养基 颗粒 Martin Agar Medium, Modified 用于药品及生物制品霉菌无菌检验
玫瑰红钠琼脂培养基 颗粒 Rose Bengal Agar Medium 用于霉菌、酵母菌计数
孟加拉红培养基 颗粒 Rose Bengal Medium 用于食品中霉菌及酵母菌总数测定
马铃薯葡萄糖琼脂(PDA)颗粒 Potato Dextrose Agar 用于霉菌酵母菌计数
胰蛋白胨大豆肉汤 颗粒 Tryptose Soya Broth 用于细菌的增菌培养,也可用于灌装线无菌试验。
胰蛋白胨大豆琼脂 颗粒 TSA Agar 用于细菌的纯化培养和产黄色素试验
10%氯化钠胰酪胨大豆肉汤 颗粒 10% NaCl Trypticase Soy Broth 用于金黄色葡萄球菌的 MPN 测定及增菌培养
11%氯化钠胰酪胨大豆肉汤 颗粒 11% NaCl Trypticase Soy Broth 用于金黄色葡萄球菌的 MPN 测定及增菌培养
伊红美蓝琼脂 (EMB) 颗粒 Eosin‐Methylene Blue Agar 弱选择性培养基、用于分离肠道致病菌,特别是大肠杆菌
缓冲蛋白胨水(BPW) 颗粒 Buffered Peptone Water 用于沙门氏菌、阪崎杆菌等菌前增菌培养
盐胱氨酸增菌液(SC)颗粒 Selenite Cystine Broth 用于沙门氏菌选择性增菌培养
四硫磺酸盐煌绿增菌液基础(TTB)颗粒 Tetrathionate Broth Base 用于沙门氏菌选择性增菌培养
SS 琼脂颗粒 SS Agar 用于沙门氏菌,志贺氏菌的选择性分离培养
7.5%氯化钠肉汤 颗粒 7.5% Sodium Chloride Broth 用于金黄色葡萄球菌的增菌培养
7.6%氯化钠肉汤 颗粒 7.6% Sodium Chloride Broth 用于金黄色葡萄球菌的增菌培养
Baird-Parker 琼脂基础 颗粒 Baird‐Parker Agar Base 用于金黄色葡萄球菌的选择性分离培养
脑心浸出液肉汤(BHI)颗粒 Brain Heart Infusion Broth 用于细菌的增菌培养或纯化培养
Fraser 培养基 颗粒 Fraser Medium 用于李氏菌的增菌培养
李氏菌增菌肉汤(LB1,LB2)基础 颗粒 Listeria Enrichment Broth Base 用于李氏菌的二步增菌
李氏菌增菌肉汤(LB1,LB3)基础 颗粒 Listeria Enrichment Broth Base 用于李氏菌的二步增菌
含 0.6%酵母浸膏的胰酪胨大豆琼脂(TSA-YE)颗粒 Trypticase Soy‐Yeast ExtractAgar 用于单增李氏菌的分纯,培养,可用于做 7%羊血琼脂
含 0.6%酵母浸膏的胰酪胨大豆肉汁(TSB-YE)颗粒 Trypticase Soy‐Yeast Extract Broth 用于单增李氏菌增菌培养
含 0.7%酵母浸膏的胰酪胨大豆肉汁(TSB-YE)颗粒 Trypticase Soy‐Yeast Extract Broth 用于单增李氏菌增菌培养
改良月桂基硫酸盐胰蛋白胨肉汤-万古霉素,(mLST-Vm) 颗粒 Modified Lauryl Sulfate Tryptose Broth‐Vancomycin Medium 用于阪崎杆菌选择性增菌培养
改良 EC 肉汤(mEC+n) Modified EC Broth 用于 O157 选择性增菌
碱性蛋白胨水 颗粒 Alkaline Peptone Water 用于霍乱弧菌选择性增菌培养
3%氯化钠碱性蛋白胨水 颗粒 3%NaCl Alkaline Peptone Water 用于副溶血性弧菌选择性增菌培养
4%氯化钠碱性蛋白胨水 颗粒 4%NaCl Alkaline Peptone Water 用于副溶血性弧菌选择性增菌培养
TCBS 琼脂颗粒 Thiosulfate Citrate Bile Salts Sucrose Agar 用于致病性弧菌的选择性分离
LB 肉汤 颗粒 LB Broth 用于基因工程菌大肠埃希氏菌菌培养
大肠杆菌显色培养基 E.Coli Chromogenic Medium 用于快速、准确检测大肠杆菌,培养 24 小时,大肠杆菌显蓝绿色
大肠杆菌显色平板(9cm) 用于快速、准确检测大肠杆菌,培养 24 小时,大肠杆菌显蓝绿色
大肠菌群显色培养基 Coliform Chromogenic Medium 用于快速、准确检测大肠杆菌,培养 24 小时,大肠杆菌显蓝绿色
大肠菌群显色平板(9cm) 大肠菌群显蓝绿色用于快速、准确同时检测大肠杆菌和大肠菌群,培养 24 小时,大肠杆菌显蓝绿色-紫色,大肠菌群显红色
大肠杆菌/大肠菌群显色培养基 E.Coli/Coliform Chromogenic Medium 大肠菌群显蓝绿色用于快速、准确同时检测大肠杆菌和大肠菌群,培养 24 小时,大肠杆菌显蓝绿色-紫色,大肠菌群显红色
大肠杆菌/大肠菌群显色平板(9cm) 大肠菌群显蓝绿色用于快速、准确同时检测大肠杆菌和大肠菌群,培养 24 小时,大肠杆菌显蓝绿色-紫色,大肠菌群显红色
大肠杆菌/大肠菌群液体显色培养基 E.Coli/Coliform Broth Chromogenic Medium 用于快速、准确同时检测大肠杆菌和大肠菌群,培养 24 小时,大肠杆菌显蓝色荧光,大肠菌群显蓝色
TBX 培养基 TBX Agar 用于快速、准确检测大肠杆菌,培养 24 小时,大肠杆菌显蓝绿色
TBX 培养基平板(9cm) 用于快速、准确检测大肠杆菌,培养 24 小时,大肠杆菌显蓝绿色
细菌总数显色培养基 Total Genes Chromogenic Medium 用于快速、准确检测菌落总数,培养 24 小时,细菌显红色
细菌总数显色平板(9cm) 用于快速、准确检测菌落总数,培养 24 小时,细菌显红色
O157 显色培养基 O157 Chromogenic Medium 用于 O157 菌的显色培养,O157 菌显亮红色、淡红色或红色
O157 显色平板(9cm) 用于 O157 菌的显色培养,O157 菌显亮红色、淡红色或红色
沙门氏菌显色培养基(第一代) Salmonella Chromogenic Medium 用于食品中沙门氏菌的显色培养,沙门氏菌显亮红色
沙门氏菌显色培养基(第二代) Salmonella Chromogenic Medium 用于沙门氏菌的显色培养,沙门氏菌显紫色
沙门氏菌显色平板(9cm) 用于沙门氏菌的显色培养,沙门氏菌显紫色
李斯特氏菌显色培养基 Listera Chromogenic Medium 用于李斯特氏菌的显色培养,单增李斯特氏菌显蓝色,外围有一不透明环
李斯特氏菌显色平板(9cm) 用于李斯特氏菌的显色培养,单增李斯特氏菌显蓝色,外围有一不透明环
金黄色葡萄球菌显色培养基 Staphylococcus Chromogenic Medium 用于金黄色葡萄球菌的显色培养,金黄色葡萄球菌显蓝绿色。
金黄色葡萄球菌显色平板(9cm) 用于金黄色葡萄球菌的显色培养,金黄色葡萄球菌显蓝绿色。
霉菌和酵母菌显色培养基 Mould and Yeast Chromogenic Medium 用于霉菌和酵母菌的显色培养。克柔假丝酵母显蓝绿色,酿酒酵母菌显蓝绿色,霉菌显棉状蓝绿色菌落,细菌被抑制
霉菌和酵母菌显色平板(9cm) 用于霉菌和酵母菌的显色培养。克柔假丝酵母显蓝绿色,酿酒酵母菌显蓝绿色,霉菌显棉状蓝绿色菌落,细菌被抑制
弧菌显色培养基 Vibrio Chromogenic Medium 用于弧菌的显色培养,副溶血性弧菌显蓝色,霍乱弧菌显红色,其它弧菌显红色或无色。
弧菌显色培养基平板(9cm) 用于弧菌的显色培养,副溶血性弧菌显蓝色,霍乱弧菌显红色,其它弧菌显红色或无色。
阪崎肠杆菌显色培养基(DFI 琼脂) Enterobacter Sakazakii Chromogenic Medium 用于阪崎杆菌的显色培养,阪崎杆菌显蓝色,其它肠杆菌显无色。
阪崎肠杆菌显色平板 (DFI 琼脂) (9cm) 用于阪崎杆菌的显色培养,阪崎杆菌显蓝色,其它肠杆菌显无色。
肠球菌显色培养基 Enterococcus Faecium Chromogenic Medium 用于阪崎肠杆菌的显色培养,阪崎肠杆菌显蓝色,其它肠杆菌显无色。
肠球菌显色平板(9cm) 用于肠球菌的显色培养,肠球菌显红色至紫红色
念珠菌显色培养基 Candida Chromogenic Medium 用于念珠菌分离和鉴定,白色念珠菌显绿色
志贺氏菌显色培养基 Shigella Chromogenic Medium 用于志贺氏菌显色培养,志贺氏菌显无色菌落,其它菌显绿色、黄色或蓝色
志贺氏菌显色平板(9cm) 用于志贺氏菌显色培养,志贺氏菌显无色菌落,其它菌显绿色、黄色或蓝色
蜡样芽孢杆菌显色培养基 Bacillus Cereus Chromogenic Medium 蜡样芽孢杆菌显蓝绿色且菌落比较大,苏云菌落比较小,其它菌显黄色或无色,革兰氏阴性菌被抑制。
蜡样芽孢杆菌显色平板(9cm) 蜡样芽孢杆菌显蓝绿色且菌落比较大,苏云菌落比较小,其它菌显黄色或无色,革兰氏阴性菌被抑制。
MEI 培养基 MEI Medium 用于一步滤膜法显色检测或计数水中的肠球菌
MI 培养基 MI Medium 用于滤膜法计数饮用水中大肠埃希氏菌和大肠菌群
EC‐MUG 培养基 EC‐MUG Medium 用于生活饮用水及其水源水中大肠埃希氏菌的检测
MUG 营养琼脂(NA‐MUG) MUG Nutrient Agar 用于滤膜法检测生活饮用水及其水源水中大肠埃希氏菌
MMO‐MUG 培养基 MMO‐MUG Medium 用于生活饮用水及其水源水中大肠菌群和大肠埃希氏菌的同时检测
MUG 培养基 MUG Medium 用于药品和生物制品中大肠埃希氏菌的检测
茜素‐β‐半乳糖苷琼脂 Aliz‐gal Agar 用于食品、饮料和饮用水中大肠菌群快速检测和计数(GB 标准)
MUGal 肉汤 MUGal Broth 用于食品、饮料和饮用水中大肠菌群快速检测计数(GB 标准)
VRB‐MUG 琼脂 VRB‐MUG Agar 用于大肠埃希氏菌的固体平板检测(GB 标准)
营养琼脂平板(9cm) Nutrient Agar Plate 细菌计数、不含糖,可作血琼脂基础和传代用
TSA 培养基平板(9cm) TSA Plate 一种通用培养基,用于各种微生物的培养,也用于奶粉中阪崎杆菌的纯化培养和产黄色素试验
3%氯化钠胰蛋白胨大豆琼脂(9cm) 3%Nacl TSA Plate 用于副溶血弧菌的纯化试验
血平皿(9cm) Blood Agar Plate 用于一般细菌的分离、培养和溶血试验
哥伦比亚血琼脂平板(9cm) Columbia Blood Agar Plate 用于营养要求高细菌的分离、培养和溶血试验
巧克力琼脂平板(9cm) Chocolate Agar Plate 用于嗜血杆菌、奈瑟氏菌分离培养
伊红美蓝琼脂平板(9cm) Eosin‐Methylene Blue Agar Plate 弱选择性培养基、用于分离肠道致病菌,特别是大肠杆菌
麦康凯琼脂平板(9cm) MacConkey Agar Plate 用于肠道致病菌的选择性分离、培养
中国蓝琼脂平板(9cm) China Blue Agar Plate 弱选择性培养基,用于肠道致病菌的选择性分离
孟加拉红培养基平板(9cm) Rose Bengal Medium Plate 用于食品中霉菌及酵母菌总数测定
结晶紫中性红胆盐琼脂平板(9cm) Violet Red Bile Agar Plate 用于大肠菌群的固体平板检测
品红亚硫酸钠琼脂平板(9cm) Fuchsin Basic Sodium Sulfide Agar Plate 用于饮用水、水源水中总大肠菌群的选择性分离和确证
MFC 琼脂平板(9cm) MFC Agar Plate 用于大肠菌群的滤膜法检测
SS 琼脂平板(9cm) Salmonella Shigella Agar Plate 用于沙门氏菌、志贺氏菌的选择性分离培养
HE 琼脂平板(9cm) Hektoen Enteric Agar Plate 用于沙门氏菌的选择性分离培养
XLD 培养基平板(9cm) Xylose Lysine Desoxycholate Medium Plate 选择性培养基,主要用于分离志贺氏菌属,亦可用于分离沙门氏菌
亚硫酸铋琼脂平板(9cm) Bismuth Sulfite Agar Plate 用于沙门氏菌的选择性分离
山梨醇麦康凯琼脂(SMAC)平板(9cm) Sorbitol Maconkey Agar Base Plate 用于大肠杆菌 O157 的分离培养
Baird‐Parker 琼脂平板(9cm) Baird‐Parker Agar Base Plate 用于金黄色葡萄球菌的选择性分离培养
牛津琼脂(OXA)平板(9cm) Oxford Agar Base Plate 用于单增李氏菌的选择性分离
PALCAM 琼脂平板(9cm) PALCAM Agar Plate 用于单增李氏菌的选择性分离
MRS 琼脂平板(9cm) MRS Agar Plate 用于食品中乳酸菌总数测定
TCBS 琼脂平板(9cm) Thiosulfate Citrate Bile Salts Sucrose Agar Plate 用于致病性弧菌的选择性分离
甘露醇卵黄多粘菌素琼脂平板(9cm) Mannitol‐Egg‐Yolk‐Polymyxin Agar Base Plate 用于蜡样芽孢杆菌的固体平板计数
庆大霉素琼脂平板(9cm) Gentamycin Agar Plate 用于霍乱弧菌的分离培养
四号琼脂平板 No.4 Agar Plate 用于霍乱弧菌的分离培养
BCYE 琼脂平板(9cm) BCYE Agar Base Plate 用于军团菌的选择性分离培养
BCYE‐CYS 琼脂平板(9cm) BCYE‐CYS Agar Plate 用于军团菌的选择性分离培养
GVPC 琼脂平板(9cm) GVPC Agar Base Plate 用于军团菌的选择性分离培养
我妻氏血琼脂平板(9cm) Wagstsuma Blood Agar Base Plate 用于神奈川现象试验
CIN‐1 琼脂平板(9cm) CIN‐1 Agar Plate 用于分离小肠结肠炎耶尔森氏菌
改良 Skirrow 氏琼脂平板(9cm) Modified Skirrow Agar Plate 用于弯曲杆菌的分离培养
改良 CCDA 琼脂平板(9cm) Modified CCDA Agar Plate 用于弯曲杆菌的分离培养
含 225ml 磷酸盐缓冲液均质袋 Phosphate Buffered Saline 用于样品制备
含 90ml 磷酸盐缓冲液均质袋 Phosphate Buffered Saline 用于样品制备
含 200ml 生理盐水均质袋 Physiological Saline 用于样品稀释处理
含 225ml 生理盐水均质袋 Physiological Saline 用于样品稀释处理
含 225ml 缓冲蛋白胨水(BPW)均质袋 Buffered Peptone Water 用于沙门氏菌、阪崎杆菌制样和前增菌培养
含 900ml 缓冲蛋白胨水(BPW)均质袋 Buffered Peptone Water 用于阪崎杆菌的定量
含 90ml 缓冲蛋白胨水(BPW)均质袋 Buffered Peptone Water 用于阪崎杆菌的定量
含 100ml 缓冲蛋白胨水(BPW)均质袋 Buffered Peptone Water 用于阪崎杆菌的定量
含 225ml 3%氯化钠碱性蛋白胨水均质袋 3% NaCl Alkaline Peptone Water 用于副溶血性弧菌的前增菌培养
含 225ml mEC+n 肉汤均质袋 mEC+n Broth 用于大肠杆菌 O157 菌前增菌培养
新生霉素 Novobiocin 每支添加于 225ml HBJ004 中
含 225ml LB1 肉汤均质袋 LB1 Broth 用于李斯特氏菌制样和前增菌培养
萘啶酮酸 Nalidixic Acid 每支添加于 225ml HBJ005 中制成LB1 肉汤
吖啶黄素 Acridine Flavin 每支添加于 225ml HBJ005 中制成LB1 肉汤
含 225ml GN 增菌液均质袋 GN Enrichment Broth 用于志贺氏菌前增菌培养
含 225ml 志贺氏菌増菌肉汤均质袋 Shigella Enrichment Broth 用于志贺氏菌前增菌培养
含 225ml 7.5%氯化钠肉汤均质袋 7.5% NaCl Broth 用于金葡菌前增菌培养
含 50ml 7.5%氯化钠肉汤均质袋 7.5% NaCl Broth
含 225ml 10%氯化钠胰酪胨大豆肉汤均质袋 10% NaCl Trypticase Soy Broth
含 225ml 布氏肉汤均质袋 Brucella Broth 用于空肠弯曲菌的前增菌
布氏肉汤添加剂(2ml/支) Brucella Broth Supplement 添加于 HBJ014 中
含 225ml Bolton 肉汤均质袋 Bolton Broth 用于空肠弯曲菌的增菌培养
含 100ml Bolton 肉汤均质袋 Bolton Broth 用于空肠弯曲菌的增菌培养
Bolton 肉汤添加剂 Bolton Broth Supplement 添加于 HBJ023-1 和 HBJ007 中
含225ml 胰酪胨大豆多粘菌素肉汤均质袋 Trypticase Soy Polymyxin Broth 用于蜡样芽孢杆菌的前增菌培养
多粘菌素 B Polymyxin B 每支添加于 225ml HBJ016 中
含 225ml 改良胰蛋白胨大豆肉汤均质贷 用于检测 ß-溶血性链球菌的样品增菌(GB 标准)
萘啶酮酸 2.25mg 每支添加于 225mlHBJ4114-20 中,
多粘菌素 B 2.25mg 每支添加于 225mlHBJ4114-20 中,
含 225ml FB1 增菌液均质袋 FB1 Broth 用于李氏菌前增菌培养
FB1(Half‐Fraser)添加剂(A、B) FB1 additive(A、B) 每支添加到 225ml HBJ006 中
0.85%无菌生理盐水 0.85% Sterile Saline 用于样品稀释处理
磷酸盐缓冲液 (PBS pH7.2) Phosphate Buffered Saline 用于菌落总数,大肠菌群,金葡菌,大肠杆菌样品制备
LST 发酵管(含小倒管) LST 用于大肠菌群、大肠杆菌的测定
月桂基硫酸盐胰蛋白胨肉汤 LST 管(双料,含小倒管) Lauryl Sulfate Tryptose Broth 用于大肠菌群、大肠杆菌的测定
EC 肉汤(含小倒管) EC Broth 用于粪大肠菌群、大肠杆菌的测定
煌绿乳糖胆盐肉汤 BGLB(含小倒管) Brilliant Green Lactose Bile Broth 用于大肠菌群、大肠杆菌的测定
双料乳糖胆盐发酵培养基管(含小倒管) Double Lactose Bile Ferment Broth 用于大肠菌群的测定
单料乳糖胆盐发酵培养基管(含小倒管) Lactose Bile Ferment Broth 用于大肠菌群、大肠杆菌的测定
乳糖蛋白胨培养液(含小倒管) Lactose Peptone Broth 用于大肠菌群、大肠杆菌的测定
双料乳糖蛋白胨培养液(含小倒管) Double Lactose Peptone Broth 用于大肠菌群、大肠杆菌的测定
缓冲蛋白胨水(BPW) Buffer peptone water(BPW) 用于沙门氏菌和阪崎杆菌的增菌
四硫磺酸盐煌绿增菌液(TTB 肉汤) TTB Broth 用于沙门氏菌选择性增菌培养
盐胱氨酸增菌液(SC) Selenite Cystine Broth 用于沙门氏菌选择性增菌培养
GN 增菌液 GN Enrichment Broth 主要用于志贺氏菌增菌培养,亦可用于沙门氏菌增菌培养
RV 肉汤 RV Broth 用于沙门氏菌选择性增菌培养
SBG 增菌液 SBG Enrichment Broth 用于沙门氏菌的增菌培养
改良月桂基硫酸盐胰蛋白胨肉汤‐万古霉素 Modified Lauryl Sulfate Tryptose Broth‐ VancoMycin Medium 用于阪崎杆菌选择性增菌培养
李氏菌增菌肉汤(LB1) Listeria Enrichment Broth Base 用于李氏菌增菌培养
李氏菌增菌肉汤(LB2) Listeria Enrichment Broth Base 用于李氏菌二步增菌
改良 EC(mEC+n)肉汤 Modified EC Enrichment Broth 用于 O157 菌选择性增菌
LST‐MUG LST‐MUG 用于 O157 菌的荧光试验
改良磷酸盐缓冲液(PBS) Phosphate Buffered Saline 用于小肠结肠炎耶尔森氏菌增菌培养
3%氯化钠碱性蛋白胨水 3%Sodium Chloride Peptone Water 副弧菌的选择性增菌
4%氯化钠碱性蛋白胨水 4%Sodium Chloride Peptone Water 副弧菌的选择性增菌
10%氯化钠胰酪胨大豆肉汤 10% NaCl Trypticase Soy Broth 用于金黄色葡萄球菌的 MPN 测定及增菌培养
11%氯化钠胰酪胨大豆肉汤 11% NaCl Trypticase Soy Broth 用于金黄色葡萄球菌的 MPN 测定及增菌培养
胰酪胨大豆多粘菌素肉汤 Trypticase‐Soy‐Polymyxin Broth Base 用于蜡样芽孢杆菌的 MPN 值测定
三糖铁管 TSI 用于肠杆菌科细菌的生化反应筛选
3%氯化钠三糖铁管 用于副溶血性弧菌的生化反应筛选
改良克氏三糖铁管 用于小肠结肠炎耶尔森氏菌的生化
MIU 培养基 MIU Medium 用于细菌的复合生化试验
金氏 B 培养基管 用于铜绿假单菌产荧光色素试验
MUG 快速鉴定大肠试剂 MUG 用于快速鉴定大肠杆菌
EC‐MUG 管 用于生活饮用水及其水源水中的大肠埃希氏菌的检测
氯、碘中和剂管 Chlorine, Iodine Neutralizer 用于消毒剂的中和
醛类中和剂管 Aldehyde Neutralizer 用于消毒剂的中和
醇类中和剂管 Alcohol Neutralizer 用于消毒剂的中和
SCDLP 液体培养基管 用于化妆品的样品制备
溴甲酚紫葡萄糖蛋白胨水管 用于压力蒸气消毒过程监测指示菌(嗜热脂肪杆菌芽孢)的培养及消毒效果测定
瓷珠菌种保存管 Strain Store Medium 用于菌种保存(瓷珠法),
液体菌种保存管 用于菌种的保存
军团菌菌种保存管 专用于军团菌的保存
Cary‐Blair 氏运送培养基 Cary‐Blair Transport Medium 用于微生物样品的采集、运送和保存,特别是空肠弯曲菌、霍乱弧菌、副溶血性弧菌、沙门氏菌和志贺氏菌等
Cary‐Blair 氏运送管(液体) Cary‐Blair Transport Medium 用于微生物样品的采集、运送和保存,特别是空肠弯曲菌、霍乱弧菌、副溶血性弧菌、沙门氏菌和志贺氏菌等
Cary‐Blair 氏运送管(40ml) Cary‐Blair Transport Medium 可同时保存 5 支采样拭子标本
Amies 运送培养基 Amies Transport Medium 用于标本采集、存放、传递。广泛用于口腔科、皮肤科、妇科、泌尿科等标本的取样
Amies 运送培养基(含活性炭) Amies Transport Medium 用于标本采集、存放、传递。广泛用于口腔科、皮肤科、妇科、泌尿科等标本的取样
Stuart 运送培养基 Stuart Transport Medium 用于标本采集、存放、传递。广泛用于口腔科、皮肤科、妇科、泌尿科等标本的取样
Stuart 运送培养基(液体) Stuart Transport Medium 主要用于咽喉、伤口等标本运送特别是奈瑟氏菌属、肺炎球菌、沙门氏菌属等标本的采取和运输
Stuart 运送培养基(含活性碳) Stuart Transport Medium 主要用于咽喉、伤口等标本运送特别是奈瑟氏菌属、肺炎球菌、沙门氏菌属等标本的采取和运输
无菌病毒运输液 (VTM) VTM Broth 用于甲流病毒标本运送
MEM 维持液 MEM maintenance of fluid 主要用于用于手足口病样品的运输
无菌采样袋(45cm*55cm) Sterile Homogeneous Bag 用于样品的采样(容量 3.5L)
无菌采样袋/均质袋(32cm*20cm)(带压条) Sterile Homogeneous Bag 用于样品的采样或均质
无菌均质袋(32cm*20cm)(不带压条) Sterile Homogeneous Bag 用于样品的均质
无菌采样袋(12cm*18cm)(带压条) Aseptic Sampling Bag 用于 50g 内固体样品的采样
无菌采样袋(带铁丝)(11.4cm*22.9cm) 用于固体或液体样品的采样
水样采集袋 Water Aseptic Sampling Bag 用于 1L 内水质的无菌采样,500ml刻度线
水样采集袋(含硫代硫酸钠) Water Aseptic Sampling Bag 用于需要中和硫代硫酸钠的生活饮用水、游泳池等水的无菌采样(含0.4mg 硫代硫酸钠),500ml 刻度线
2.5L包 每只用于 2.5L
2.5L气袋 每只用于 2.5L
氧气指示剂 用于厌氧系统中氧气指示
350ml 厌氧产气包 每只用于 350ml
350ml 厌氧培养袋 可装 2-4 个培养皿
2.5L圆底立式厌氧培养袋 可装 12 个培养皿
LB 肉汤(Miller) LB Broth(Miller) 用于基因工程菌大肠埃希氏菌培养
LB 肉汤(Lennox) LB Broth(Lennox) 用于基因工程菌大肠埃希氏菌培养
LB 营养琼脂 LB Agar 用于基因工程菌大肠埃希氏菌培养
SOB 培养基 SOB Medium 用于基因工程菌大肠埃希氏菌培养
SOC 培养基 用于基因工程菌大肠埃希氏菌培养
2×YT 肉汤 2×YT Broth 用于基因工程菌大肠埃希氏菌培养
TB 培养基 Terrific Broth 用于基因工程菌大肠埃希氏菌培养
SB 培养基 Super Broth 用于大肠埃希菌产纤毛抗体培养,属细菌疫苗培养基
改良 mincal 肉汤 用于大肠埃希菌产纤毛抗体培养,属细菌疫苗培养基
HB‐PE 自诱导培养基 HB‐PET Auto Express Medium 用于基因工程菌大肠埃希氏菌诱导蛋白
YNB 培养基 YNB Medium 用于基因工程中酵母菌的发酵培养
蛋白高效表达培养基 用于基因工程大肠杆菌高效表达外源蛋
磷酸盐缓冲液(PH7.2) PBS Broth 用于样品的稀释、制备等同生理盐水
营养琼脂 (NA) Nutrient Agar 细菌计数、不含糖,可作血琼脂基础和传代用
平板计数琼脂(PCA) Plate Count Agar 国际标准平板计数琼脂,含糖,用于细菌总数的测定
嗜冷菌计数琼脂(乳平板计数琼脂) Psychrophilic Bacteria Count Agar 用于奶制品中嗜冷微生物的菌落总数测定
MPC 琼脂培养基(改良平板计数琼脂) MPC Agar Medium 用于奶制品中菌落总数测定(阻抗法)
营养肉汤 (NB) Nutrient Broth 一般细菌培养、转种、复壮、增菌等
胰蛋白胨大豆琼脂(TSA) TSA Agar 一种通用培养基,用于各种微生物的培养,也用于奶粉中阪崎杆菌的纯化培养和产黄色素试验
TTC 营养琼脂 TTC Nutrient Agar 用于细菌总数测定
2216E 琼脂 2216E Agar 用于海生细菌的培养和计数
2216E 液体培养基 2216E Broth 用于海生细菌的培养
标准 I 号营养琼脂 Standard I Nutrient Agar 标准细菌计数、含糖
酵母粉琼脂 Yeast Extract Agar 用于水中细菌、酵母菌、霉菌菌落总数的检测(ISO9038 标准)
胰胨大豆胨固绿琼脂 Tryptic Soy Fast Green Agar 用于滤膜法细菌总数的测定和分离培养(NEOGEN 方法)
m‐TGE 肉汤 m‐TGE Broth 用于奶制品中滤膜法细菌总数计数
水平板计数琼脂培养基 Water Plate Count Agar 用于饲料中细菌总数测定
R2A 琼脂 R2A Agar 用于饮用水中细菌总数测定(USP、EP方法)
接触皿培养基 Min Media Contacts 用于生产环境的菌落总数检测
CVT 琼脂 CVT Agar 用于乳制品中嗜冷菌的计数培养三天即可
WL 营养琼脂 WL Nutrient Agar 用于啤酒和发酵产品中酵母菌和细菌的计数
LG 培养基 LG medium 用于霉菌、酵母菌、耐热霉菌及细菌总数检测,以及 PET 瓶、无菌罐装生产线
孟加拉红培养基 (虎红琼脂) Rose Bengal Medium 用于食品中霉菌及酵母菌总数测定
马铃薯葡萄糖琼脂 (PDA) Potato Dextrose Agar 用于霉菌、酵母菌计数
马铃薯葡萄糖琼脂(含氯霉素) Potato Dextrose Agar(Chloramphenicol) 用于霉菌、酵母菌计数
30%葡萄糖溶液(PH6.5±0.5) 30% Dextrose Broth 用于蜂蜜样品的处理和稀释
氯硝胺 18%甘油(DG18)琼脂 DG18 Agar 用于蜂蜜中嗜渗酵母计数(GB14963-2011)
氯霉素溶液(20mg) Chloramphenicol Solution 每支添加于 200ml 的基础液中
察氏琼脂 Czapek Dox Agar 用于青霉、曲霉鉴定及保存菌种用(GB标准)
产毒培养基 Toxin‐Producing Medium 用于青霉、曲霉的产毒培养
马铃薯葡萄糖水 Potato Dextrose Medium 用于椰毒假单胞酵米面亚种和真菌的增菌培养(GB 标准)
马铃薯葡萄糖半固体琼脂 Potato Dextrose Semi‐solid Agar 用于椰毒假单胞酵米面亚种的产毒培养(GB 标准)
高盐察氏琼脂 Salt Czapek Dox Agar 用于饲料中霉菌的计数(GB 标准)
沙氏琼脂培养基 Sabouraud’s Agar 用于真菌检测 (GB 标准)
霉菌培养基(含琼脂和氯霉素) Fungal Medium 用于霉菌的分离培养
土霉素麦芽提取物琼脂培养基 Oxytetracycline Malt ExtractAgar Medium 用于真菌的分离培养
玉米粉琼脂 Corn Meat Medium 用于真菌培养及鉴定
TTC‐沙堡罗培养基 TTC‐Sha Baoluo Medium 用于分离真菌、酵母菌等
酵母粉葡萄糖氯霉素琼脂(YDC) Yeast Extract DextroseChloramphenicol Agar 用于食品中霉菌及酵母菌总数测定
酵母浸出物葡萄糖土霉素琼脂培养基 Yeast Extract GlucoseOxytetracycline Agar 用于乳及乳品霉菌、酵母菌计数(SNT 2552.3)
Candida Elective 琼脂 Candida Elective Agar to Nickerson 用于食品中念珠菌及酵母菌总数测定
DTM 培养基 DTM Medium 用于食品中真菌的培养
DRBC 琼脂 DRBC Agar 用于食品中霉菌及酵母菌分离培养
WORT 琼脂 Wort Agar 用于真菌,特别是酵母菌的计数
WORT 肉汤 Wort Broth 用于真菌,特别是酵母菌的培养
YGC 琼脂 YGC Agar 用于奶和奶制品中霉菌及酵母菌分离培
改良绿色酵母菌和真菌肉汤 m‐GREEN YEAST and FUNGI BROTH 用于啤酒、饮料等滤膜法真菌及酵母菌
Littman 琼脂 Littman Agar 用于真菌的分离培养
DG‐18 琼脂 DG‐18 Agar 用于食品中霉菌和酵母菌分离培养
YM 琼脂 YM Agar 用于霉菌、酵母菌及耐酸菌的分离培养
YM 培养基 YM Medium 用于霉菌和酵母菌的增菌培养
YM11 琼脂 YM11 Agar 滤膜法用于霉菌、酵母菌的分离培养
OGY 琼脂 OGY Agar 用于霉菌和酵母菌分离培养和计数
改良沙氏琼脂培养基 Sabouraud’s Agar,Modified 用于真菌检测
沙氏 BHI 琼脂 Sabouraud BHI Agar 用于真菌检测
营养盐琼脂 Nutrient Agar 用于纺织中检验材料耐真菌、霉菌的效能
1%吐温 80‐玉米琼脂培养基 1%Tween80‐Corn Meat Agar Mediun 用于白色念珠菌产芽管试验
麦芽浸膏琼脂(MEA) Malt Extract Broth 用于霉菌和酵母菌的分离培养和计数
麦芽浸膏汤(MEB) Malt Extract Broth 用于霉菌和酵母菌的培养
麦芽汁琼脂 Wort Agar 用于霉菌和酵母菌的培养
BIGGY 琼脂BIGGY agar 用于念珠菌的分离培养和计数
皮肤癣菌鉴别琼脂(DTM) DTM Agar 用于皮肤癣菌鉴别培养
WLN 培养基 WLN Medium 用于酿造和工业发酵过程中细菌、酵母菌和霉菌培养
改良察氏液体培养基 Modified Czapek Liquid Medium 用于霉菌的增菌培养基(GB 标准)
面包酵母标准培养基 Baker Yeast Standard Medium 用于面包酵母计数培养
野生酵母培养基 Wild Yeast Medium 用于野生酵母计数培养
月桂基硫酸盐胰蛋白胨肉汤(LST) Lauryl Sulfate Tryptose Broth 用于 MPN 法大肠菌群,大肠埃希氏菌的测定(GB、SN 标准)
双料月桂基硫酸盐胰蛋白胨肉汤(LST) Lauryl Sulfate Tryptose Broth 用于大肠菌群, 大肠埃希氏菌的测定(GB、SN 标准)
煌绿乳糖胆盐肉汤 (BGLB) Brilliant Green Lactose Bile Broth 用于大肠菌群、大肠埃希氏菌的测定(GB、SN 标准)
EC 肉汤 E.Coli Broth 用于粪大肠菌群、大肠埃希氏菌的测定(GB、SN 标准)
伊红美蓝琼脂 (EMB) Eosin‐Methylene Blue Agar 弱选择性培养基、用于分离肠道致病菌,特别是大肠杆菌(GB、SN 标准)
乳糖胆盐发酵培养基 Lactose Bile Broth 用于大肠菌群,粪大肠菌群,大肠埃希氏菌的测定(GB 标准)
乳糖复发酵培养基 Lactose Broth 用于大肠菌群,粪大肠菌群, 大肠埃希氏菌的测定(GB 标准)
去氧胆酸盐琼脂(DC)&nbs
产品性状:请联系客服人员
储存条件:详情参考说明书
联系电话:15527510518 18163548455 13296670271 13296673586
QQ:1546342329 3176445674
武汉纯度生物科技有限公司,主要销售常用抗原抗体、试剂、Elisa试剂盒、生化试剂盒、免疫检测试剂盒、金标试剂盒、金标检测卡、动物血清、血浆、全血、抗血清、毒素类标准品、生物试剂、培养基、实验室仪器耗材、化学试剂、生物制品、标准品、对照品、生化免疫制品、免疫亲和柱、菌株、质粒、室内质控品、细胞、培养基、PEG、病理染色液、免疫学试剂、蛋白组学试剂、细胞生物学试剂、分子生物学试剂、抑制剂、细胞因子等。武汉纯度生物时刻谨记产品质量,正如公司名一样,达到“专业规格,纯度保证”的质量生命线。公司秉承“客户为天,质量为根,诚信为本,创新为魂”的信念,将以优质的产品,完善的服务,为每一位客户的实验保驾护航。
ELISA酶联免疫试剂盒有(牛、马、山羊、绵羊、人、狗、兔、鸡、豚鼠、猪、植物、猴子、大鼠、小鼠、鱼,虾蟹,菌类等)种属相关试剂盒,食品安全类检测试剂盒(黄曲霉毒素B1 elisa检测试剂盒、呕吐毒素elisa检测试剂盒、桔青霉素elisa检测试剂盒等)农药残留检测试剂盒厂家直销、指标齐全、种类齐全、可提供免费代测、提供技术支持、品质可靠、价格优势,欢迎咨询合作。
生化试剂盒(植物激素类、土壤类、谷胱甘肽类、蛋白酶类、蔗糖、淀粉类试剂盒、氨基酸代谢类、脂酶类)分光光度法试剂盒,微量法试剂盒、气相试剂盒,液相试剂盒、DNA提取试剂盒等、乳胶增强免疫比浊法、双缩脲等方法试剂盒,乙肝甲肝梅毒等胶体快速检测卡、试剂条。
血液制品:各种动物血清(人血清、新生牛血清、标准马血清、特级马血清、山羊血清、绵羊血清、兔血清、鸡血清、大牛血清、小牛血清、猪血清、狗血清、猫血清、鱼血清、驴血清、豚鼠血清、大鼠血清、小鼠血清、SD鼠血清、巴比西鼠血清)满足各种实验需求。
动物血浆:人血浆、新生牛血浆、大牛血浆、小牛血浆、绵羊血浆、山羊血浆、猪浆、驴血浆、马血浆、狗血浆、大鼠血浆、小鼠血浆、豚鼠血浆、兔血浆、空白小鼠血浆、空白大鼠血浆、SD大鼠血浆等等。
动物红细胞:绵羊红细胞、兔血红细胞、鸡血红细胞、豚鼠血红细胞等、SPF级鸡红细胞、(1%2%3%4%6%10%20%)浓度可定做。
抗凝脱纤维抗凝血:人血、猪血、羊血、鸡血、鸭血、马血、驴血、牛血、狗血、猫血等,均为无菌包装,保质期一个月,血源可靠,品质保障,抗凝剂(柠檬酸钠/肝素钠/EDTA k2/草酸钾/阿氏液)均可定制。
毒素标准品、:N-二乙基亚硝胺(标准品/试剂)环氧化苯并芘(规格齐全)Aflatoxin B1黄曲霉毒素B1标准品(以色列原装进口,带证书,纯度99.8%)、Aflatoxin B2黄曲霉毒素B2、Aflatoxin G1黄曲霉毒素G1、Aflatoxin G2黄曲霉毒素G2、Aflatoxin M1黄曲霉毒素M1、Aflatoxin M2黄曲霉毒素M2、Deoxynivalenol脱氧雪腐镰刀菌烯醇(DON)、3-Acetyl-Deoxynivalenol3-乙酰基脱氧雪腐镰刀菌烯醇(3-A-DON)、15-Acetyl-Deoxynivalenol 15-乙酰基脱氧雪腐镰刀菌烯醇(15-A-DON)、Nivalenol雪腐镰刀菌烯醇(NIV)、Fumonisin B1 伏马毒素B1、Fumonisin B2 伏马毒素B2、Ochratoxin A 赭曲霉毒素A、Zearalenone玉米赤霉烯酮、T2 Toxin T-2 毒素、Citrinin桔青霉素/桔霉素、Patulin棒曲霉素/展青霉素标准品、Sterigmatocystin杂色曲霉素等,药物标准品,中检所标准品,详情咨询客服!
食品安全农药残留抗原抗体等实验室常用于胶体金、ELISA、免疫等体外免疫诊断原料:地塞米松抗原抗体、喹乙醇抗原抗体、红霉素抗原抗体、黄曲霉毒素B1单克隆抗体、青霉素结合蛋白、红霉素-BSA抗原抗体、孔雀石绿抗原抗体、三聚氰胺(MEL)单抗、三聚氰胺单克隆抗体、雌三醇的抗原抗体原料、赭曲霉毒素抗原抗体、黄曲霉毒素M1抗原抗体、莱克多巴胺偶联抗原、微囊藻毒素抗原抗体、地塞米松抗原抗体、雌二醇(E2)抗原抗体、呕吐毒素单克隆抗体、伏马毒素单克隆抗体等,可用于用于IVD的研发,满足各种实验
动物疫病类抗原抗体:抗猪传染性胃肠炎病毒(TGEV)单克隆抗体、抗弓型虫(Toxo)单克隆抗体、、抗轮状病毒单克隆抗体、抗沙门氏菌单克隆抗体、抗鼠伤寒沙门氏菌单克隆抗体、抗牛冠状病毒单克隆抗体、抗牛布鲁氏菌单克隆抗体、抗传染性支气管炎病毒(IBV)单克隆抗体、抗传染性法氏囊病毒(IBDV)单克隆抗体、抗甲型流感H5亚型单克隆抗体、抗甲型流感H7单克隆抗体、抗狂犬病毒(RV)单克隆抗体、抗狂犬病毒N蛋白单克隆抗体、抗犬瘟热单克隆抗体、抗犬细小单克隆抗体、抗猪流行性腹泻单克隆抗体、小反刍兽疫N蛋白单克隆抗体、抗弓形虫单抗(Toxo)、抗猪圆环病毒抗原抗体、猪蓝耳病毒抗原抗体、猪口蹄疫病毒蛋白抗体、猪伪狂犬病毒重组蛋白等。
常用诊断试剂用原料抗原-抗体(肿瘤标志物类、传染病类、心肌标志物类、优生及不孕不育类、生化免疫类原料、免疫球蛋白类、肝肾功能疾病类、激素、胰岛素类)蛋白质、多肽

公司销售单克隆抗体、多克隆抗体、标记类抗原抗体、免疫血清、抗血清、酶标记二抗IgG,荧光标记二抗IgG,阳性阴性参考血清(鸡抗HBsAg、驴抗羊IgG、驴抗兔IgG、驴抗HBsAg、豚鼠抗HBsAg、豚鼠抗羊IgG、豚鼠抗驴IgG-IgG、豚鼠抗人IgG、羊抗鼠IgG、羊抗鼠IgA、羊抗鼠IgM、羊抗鼠IgG3、羊抗鼠IgG2b、羊抗兔IgG、羊抗人IgG、兔抗鼠IgG、兔抗人IgG、兔抗鸡IgY、兔抗鸡IgY、兔抗大鼠IgG、兔抗羊IgG、兔抗人-IgG、人IGG、抗人a1AT血清、兔抗人全血清、羊抗马IgG血清、羊抗牛IgG血清、羊抗狗IgG血清、羊抗猪IgG血清、羊抗猫IgG血清、兔抗人IgA血清、兔抗人IgM血清、羊抗人IgG荧光抗体、羊抗兔IgG荧光抗体、兔抗绵羊红细胞(溶血素)、冻干抗人IgA血清、冻干羊抗人IgM血清、冻干羊抗人C3血清、冻干羊抗人C4血清、冻干羊抗人C3C血清、HRP标记羊抗人IgM、HRP标记羊抗人IgA、HRP标记羊抗人IgG+IgM+IgA、HRP标记羊抗人白蛋白、HRP标记羊抗HBsAg、HRP标记羊抗HBsAg-ALP标记、HRP标记羊抗人PSA、HRP标记羊抗人CEA、HRP标记羊抗人AFP、HRP标记羊抗人CA125、HRP标记羊抗铁蛋白IgG、HRP标记羊抗人CA199、HRP标记羊抗人血红蛋白、HRP标记羊抗人前白蛋白、HRP标记羊抗人载脂蛋白A1、HRP标记羊抗人载脂蛋白B、HRP标记羊抗人急性反应蛋白)等。
公司销售免疫组化常用试剂、细胞生物学试剂、分子生物学试剂、亲和层析柱、分子试剂盒,缓冲液染色液蛋白质Marker,细胞,多肽,培养基,产品保证质量,售后稳定,规格齐全尽在武汉纯度生物。
实验材料太多无法一一介绍,公司能为生命科学领域的广大科研人员提供数万种抗体、数千种蛋白以及相关检测试剂盒等。公司产品数量充足,试剂盒类目,抗原抗体等材料多达上万种,其他生物实验试剂耗材备货充足,可随时为广大科研人员提供所需产品。具体产品请联系销售人员,支持淘宝订货。
公司可提供正规发票!
热线电话:15527510518
公司电话:027-65382163
QQ:1546342329/3176445674
企业支付宝:1546342329@qq.com
对公账户:武汉纯度生物科技有限公司127910161310301
开户银行:招商银行武汉光谷支行
平板计数琼脂(PCA)颗粒 Plate Count Agar 国际标准平板计数琼脂,含糖,用于细菌总数的测定
营养肉汤(NB)颗粒 Nutrient Broth 一般细菌培养、转种、复壮、增菌
营养琼脂(NA)颗粒 Nutrient Agar 细菌计数、不含糖,可作血琼脂基础和传代用
月桂基硫酸盐胰蛋白胨肉汤(LST)颗粒 Lauryl Sulfate Tryptose Broth 用于大肠菌群,大肠埃希氏菌的测定
煌绿乳糖胆盐肉汤(BGLB) 颗粒 Brilliant Green Lactose Bile Broth 用于大肠菌群,大肠埃希氏菌的测定
乳糖胆盐发酵培养基颗粒 Brilliant Green Lactose Bile Broth 用于大肠菌群,粪大肠菌群,大肠埃希氏菌的测定
结晶紫中性红胆盐琼脂(VRBA)颗粒 Violet Red Bile Agar 用于大肠菌群的固体平板检测
乳糖蛋白胨培养液 颗粒 Lactose Peptone Broth 用于饮用水,水源水中总大肠菌群的测定
麦康凯琼脂 颗粒 MacConkey Agar Medium 用于肠道致病菌的选择性分离培养
麦康凯肉汤 颗粒 MacConkey Broth Medium 用于肠道致病菌的增菌培养
EC 肉汤 颗粒 E.Coli Broth 用于粪大肠菌群、大肠埃希氏菌的测定
液体硫乙醇酸盐培养基颗粒 Thioglycollate Medium 用于药品,生物制品无菌试验,用于需氧菌、厌氧菌的培养
改良马丁培养基 颗粒 Martin Medium, Modified 用于药品及生物制品霉菌无菌检验
改良马丁琼脂培养基 颗粒 Martin Agar Medium, Modified 用于药品及生物制品霉菌无菌检验
玫瑰红钠琼脂培养基 颗粒 Rose Bengal Agar Medium 用于霉菌、酵母菌计数
孟加拉红培养基 颗粒 Rose Bengal Medium 用于食品中霉菌及酵母菌总数测定
马铃薯葡萄糖琼脂(PDA)颗粒 Potato Dextrose Agar 用于霉菌酵母菌计数
胰蛋白胨大豆肉汤 颗粒 Tryptose Soya Broth 用于细菌的增菌培养,也可用于灌装线无菌试验。
胰蛋白胨大豆琼脂 颗粒 TSA Agar 用于细菌的纯化培养和产黄色素试验
10%氯化钠胰酪胨大豆肉汤 颗粒 10% NaCl Trypticase Soy Broth 用于金黄色葡萄球菌的 MPN 测定及增菌培养
11%氯化钠胰酪胨大豆肉汤 颗粒 11% NaCl Trypticase Soy Broth 用于金黄色葡萄球菌的 MPN 测定及增菌培养
伊红美蓝琼脂 (EMB) 颗粒 Eosin‐Methylene Blue Agar 弱选择性培养基、用于分离肠道致病菌,特别是大肠杆菌
缓冲蛋白胨水(BPW) 颗粒 Buffered Peptone Water 用于沙门氏菌、阪崎杆菌等菌前增菌培养
盐胱氨酸增菌液(SC)颗粒 Selenite Cystine Broth 用于沙门氏菌选择性增菌培养
四硫磺酸盐煌绿增菌液基础(TTB)颗粒 Tetrathionate Broth Base 用于沙门氏菌选择性增菌培养
SS 琼脂颗粒 SS Agar 用于沙门氏菌,志贺氏菌的选择性分离培养
7.5%氯化钠肉汤 颗粒 7.5% Sodium Chloride Broth 用于金黄色葡萄球菌的增菌培养
7.6%氯化钠肉汤 颗粒 7.6% Sodium Chloride Broth 用于金黄色葡萄球菌的增菌培养
Baird-Parker 琼脂基础 颗粒 Baird‐Parker Agar Base 用于金黄色葡萄球菌的选择性分离培养
脑心浸出液肉汤(BHI)颗粒 Brain Heart Infusion Broth 用于细菌的增菌培养或纯化培养
Fraser 培养基 颗粒 Fraser Medium 用于李氏菌的增菌培养
李氏菌增菌肉汤(LB1,LB2)基础 颗粒 Listeria Enrichment Broth Base 用于李氏菌的二步增菌
李氏菌增菌肉汤(LB1,LB3)基础 颗粒 Listeria Enrichment Broth Base 用于李氏菌的二步增菌
含 0.6%酵母浸膏的胰酪胨大豆琼脂(TSA-YE)颗粒 Trypticase Soy‐Yeast ExtractAgar 用于单增李氏菌的分纯,培养,可用于做 7%羊血琼脂
含 0.6%酵母浸膏的胰酪胨大豆肉汁(TSB-YE)颗粒 Trypticase Soy‐Yeast Extract Broth 用于单增李氏菌增菌培养
含 0.7%酵母浸膏的胰酪胨大豆肉汁(TSB-YE)颗粒 Trypticase Soy‐Yeast Extract Broth 用于单增李氏菌增菌培养
改良月桂基硫酸盐胰蛋白胨肉汤-万古霉素,(mLST-Vm) 颗粒 Modified Lauryl Sulfate Tryptose Broth‐Vancomycin Medium 用于阪崎杆菌选择性增菌培养
改良 EC 肉汤(mEC+n) Modified EC Broth 用于 O157 选择性增菌
碱性蛋白胨水 颗粒 Alkaline Peptone Water 用于霍乱弧菌选择性增菌培养
3%氯化钠碱性蛋白胨水 颗粒 3%NaCl Alkaline Peptone Water 用于副溶血性弧菌选择性增菌培养
4%氯化钠碱性蛋白胨水 颗粒 4%NaCl Alkaline Peptone Water 用于副溶血性弧菌选择性增菌培养
TCBS 琼脂颗粒 Thiosulfate Citrate Bile Salts Sucrose Agar 用于致病性弧菌的选择性分离
LB 肉汤 颗粒 LB Broth 用于基因工程菌大肠埃希氏菌菌培养
大肠杆菌显色培养基 E.Coli Chromogenic Medium 用于快速、准确检测大肠杆菌,培养 24 小时,大肠杆菌显蓝绿色
大肠杆菌显色平板(9cm) 用于快速、准确检测大肠杆菌,培养 24 小时,大肠杆菌显蓝绿色
大肠菌群显色培养基 Coliform Chromogenic Medium 用于快速、准确检测大肠杆菌,培养 24 小时,大肠杆菌显蓝绿色
大肠菌群显色平板(9cm) 大肠菌群显蓝绿色用于快速、准确同时检测大肠杆菌和大肠菌群,培养 24 小时,大肠杆菌显蓝绿色-紫色,大肠菌群显红色
大肠杆菌/大肠菌群显色培养基 E.Coli/Coliform Chromogenic Medium 大肠菌群显蓝绿色用于快速、准确同时检测大肠杆菌和大肠菌群,培养 24 小时,大肠杆菌显蓝绿色-紫色,大肠菌群显红色
大肠杆菌/大肠菌群显色平板(9cm) 大肠菌群显蓝绿色用于快速、准确同时检测大肠杆菌和大肠菌群,培养 24 小时,大肠杆菌显蓝绿色-紫色,大肠菌群显红色
大肠杆菌/大肠菌群液体显色培养基 E.Coli/Coliform Broth Chromogenic Medium 用于快速、准确同时检测大肠杆菌和大肠菌群,培养 24 小时,大肠杆菌显蓝色荧光,大肠菌群显蓝色
TBX 培养基 TBX Agar 用于快速、准确检测大肠杆菌,培养 24 小时,大肠杆菌显蓝绿色
TBX 培养基平板(9cm) 用于快速、准确检测大肠杆菌,培养 24 小时,大肠杆菌显蓝绿色
细菌总数显色培养基 Total Genes Chromogenic Medium 用于快速、准确检测菌落总数,培养 24 小时,细菌显红色
细菌总数显色平板(9cm) 用于快速、准确检测菌落总数,培养 24 小时,细菌显红色
O157 显色培养基 O157 Chromogenic Medium 用于 O157 菌的显色培养,O157 菌显亮红色、淡红色或红色
O157 显色平板(9cm) 用于 O157 菌的显色培养,O157 菌显亮红色、淡红色或红色
沙门氏菌显色培养基(第一代) Salmonella Chromogenic Medium 用于食品中沙门氏菌的显色培养,沙门氏菌显亮红色
沙门氏菌显色培养基(第二代) Salmonella Chromogenic Medium 用于沙门氏菌的显色培养,沙门氏菌显紫色
沙门氏菌显色平板(9cm) 用于沙门氏菌的显色培养,沙门氏菌显紫色
李斯特氏菌显色培养基 Listera Chromogenic Medium 用于李斯特氏菌的显色培养,单增李斯特氏菌显蓝色,外围有一不透明环
李斯特氏菌显色平板(9cm) 用于李斯特氏菌的显色培养,单增李斯特氏菌显蓝色,外围有一不透明环
金黄色葡萄球菌显色培养基 Staphylococcus Chromogenic Medium 用于金黄色葡萄球菌的显色培养,金黄色葡萄球菌显蓝绿色。
金黄色葡萄球菌显色平板(9cm) 用于金黄色葡萄球菌的显色培养,金黄色葡萄球菌显蓝绿色。
霉菌和酵母菌显色培养基 Mould and Yeast Chromogenic Medium 用于霉菌和酵母菌的显色培养。克柔假丝酵母显蓝绿色,酿酒酵母菌显蓝绿色,霉菌显棉状蓝绿色菌落,细菌被抑制
霉菌和酵母菌显色平板(9cm) 用于霉菌和酵母菌的显色培养。克柔假丝酵母显蓝绿色,酿酒酵母菌显蓝绿色,霉菌显棉状蓝绿色菌落,细菌被抑制
弧菌显色培养基 Vibrio Chromogenic Medium 用于弧菌的显色培养,副溶血性弧菌显蓝色,霍乱弧菌显红色,其它弧菌显红色或无色。
弧菌显色培养基平板(9cm) 用于弧菌的显色培养,副溶血性弧菌显蓝色,霍乱弧菌显红色,其它弧菌显红色或无色。
阪崎肠杆菌显色培养基(DFI 琼脂) Enterobacter Sakazakii Chromogenic Medium 用于阪崎杆菌的显色培养,阪崎杆菌显蓝色,其它肠杆菌显无色。
阪崎肠杆菌显色平板 (DFI 琼脂) (9cm) 用于阪崎杆菌的显色培养,阪崎杆菌显蓝色,其它肠杆菌显无色。
肠球菌显色培养基 Enterococcus Faecium Chromogenic Medium 用于阪崎肠杆菌的显色培养,阪崎肠杆菌显蓝色,其它肠杆菌显无色。
肠球菌显色平板(9cm) 用于肠球菌的显色培养,肠球菌显红色至紫红色
念珠菌显色培养基 Candida Chromogenic Medium 用于念珠菌分离和鉴定,白色念珠菌显绿色
志贺氏菌显色培养基 Shigella Chromogenic Medium 用于志贺氏菌显色培养,志贺氏菌显无色菌落,其它菌显绿色、黄色或蓝色
志贺氏菌显色平板(9cm) 用于志贺氏菌显色培养,志贺氏菌显无色菌落,其它菌显绿色、黄色或蓝色
蜡样芽孢杆菌显色培养基 Bacillus Cereus Chromogenic Medium 蜡样芽孢杆菌显蓝绿色且菌落比较大,苏云菌落比较小,其它菌显黄色或无色,革兰氏阴性菌被抑制。
蜡样芽孢杆菌显色平板(9cm) 蜡样芽孢杆菌显蓝绿色且菌落比较大,苏云菌落比较小,其它菌显黄色或无色,革兰氏阴性菌被抑制。
MEI 培养基 MEI Medium 用于一步滤膜法显色检测或计数水中的肠球菌
MI 培养基 MI Medium 用于滤膜法计数饮用水中大肠埃希氏菌和大肠菌群
EC‐MUG 培养基 EC‐MUG Medium 用于生活饮用水及其水源水中大肠埃希氏菌的检测
MUG 营养琼脂(NA‐MUG) MUG Nutrient Agar 用于滤膜法检测生活饮用水及其水源水中大肠埃希氏菌
MMO‐MUG 培养基 MMO‐MUG Medium 用于生活饮用水及其水源水中大肠菌群和大肠埃希氏菌的同时检测
MUG 培养基 MUG Medium 用于药品和生物制品中大肠埃希氏菌的检测
茜素‐β‐半乳糖苷琼脂 Aliz‐gal Agar 用于食品、饮料和饮用水中大肠菌群快速检测和计数(GB 标准)
MUGal 肉汤 MUGal Broth 用于食品、饮料和饮用水中大肠菌群快速检测计数(GB 标准)
VRB‐MUG 琼脂 VRB‐MUG Agar 用于大肠埃希氏菌的固体平板检测(GB 标准)
营养琼脂平板(9cm) Nutrient Agar Plate 细菌计数、不含糖,可作血琼脂基础和传代用
TSA 培养基平板(9cm) TSA Plate 一种通用培养基,用于各种微生物的培养,也用于奶粉中阪崎杆菌的纯化培养和产黄色素试验
3%氯化钠胰蛋白胨大豆琼脂(9cm) 3%Nacl TSA Plate 用于副溶血弧菌的纯化试验
血平皿(9cm) Blood Agar Plate 用于一般细菌的分离、培养和溶血试验
哥伦比亚血琼脂平板(9cm) Columbia Blood Agar Plate 用于营养要求高细菌的分离、培养和溶血试验
巧克力琼脂平板(9cm) Chocolate Agar Plate 用于嗜血杆菌、奈瑟氏菌分离培养
伊红美蓝琼脂平板(9cm) Eosin‐Methylene Blue Agar Plate 弱选择性培养基、用于分离肠道致病菌,特别是大肠杆菌
麦康凯琼脂平板(9cm) MacConkey Agar Plate 用于肠道致病菌的选择性分离、培养
中国蓝琼脂平板(9cm) China Blue Agar Plate 弱选择性培养基,用于肠道致病菌的选择性分离
孟加拉红培养基平板(9cm) Rose Bengal Medium Plate 用于食品中霉菌及酵母菌总数测定
结晶紫中性红胆盐琼脂平板(9cm) Violet Red Bile Agar Plate 用于大肠菌群的固体平板检测
品红亚硫酸钠琼脂平板(9cm) Fuchsin Basic Sodium Sulfide Agar Plate 用于饮用水、水源水中总大肠菌群的选择性分离和确证
MFC 琼脂平板(9cm) MFC Agar Plate 用于大肠菌群的滤膜法检测
SS 琼脂平板(9cm) Salmonella Shigella Agar Plate 用于沙门氏菌、志贺氏菌的选择性分离培养
HE 琼脂平板(9cm) Hektoen Enteric Agar Plate 用于沙门氏菌的选择性分离培养
XLD 培养基平板(9cm) Xylose Lysine Desoxycholate Medium Plate 选择性培养基,主要用于分离志贺氏菌属,亦可用于分离沙门氏菌
亚硫酸铋琼脂平板(9cm) Bismuth Sulfite Agar Plate 用于沙门氏菌的选择性分离
山梨醇麦康凯琼脂(SMAC)平板(9cm) Sorbitol Maconkey Agar Base Plate 用于大肠杆菌 O157 的分离培养
Baird‐Parker 琼脂平板(9cm) Baird‐Parker Agar Base Plate 用于金黄色葡萄球菌的选择性分离培养
牛津琼脂(OXA)平板(9cm) Oxford Agar Base Plate 用于单增李氏菌的选择性分离
PALCAM 琼脂平板(9cm) PALCAM Agar Plate 用于单增李氏菌的选择性分离
MRS 琼脂平板(9cm) MRS Agar Plate 用于食品中乳酸菌总数测定
TCBS 琼脂平板(9cm) Thiosulfate Citrate Bile Salts Sucrose Agar Plate 用于致病性弧菌的选择性分离
甘露醇卵黄多粘菌素琼脂平板(9cm) Mannitol‐Egg‐Yolk‐Polymyxin Agar Base Plate 用于蜡样芽孢杆菌的固体平板计数
庆大霉素琼脂平板(9cm) Gentamycin Agar Plate 用于霍乱弧菌的分离培养
四号琼脂平板 No.4 Agar Plate 用于霍乱弧菌的分离培养
BCYE 琼脂平板(9cm) BCYE Agar Base Plate 用于军团菌的选择性分离培养
BCYE‐CYS 琼脂平板(9cm) BCYE‐CYS Agar Plate 用于军团菌的选择性分离培养
GVPC 琼脂平板(9cm) GVPC Agar Base Plate 用于军团菌的选择性分离培养
我妻氏血琼脂平板(9cm) Wagstsuma Blood Agar Base Plate 用于神奈川现象试验
CIN‐1 琼脂平板(9cm) CIN‐1 Agar Plate 用于分离小肠结肠炎耶尔森氏菌
改良 Skirrow 氏琼脂平板(9cm) Modified Skirrow Agar Plate 用于弯曲杆菌的分离培养
改良 CCDA 琼脂平板(9cm) Modified CCDA Agar Plate 用于弯曲杆菌的分离培养
含 225ml 磷酸盐缓冲液均质袋 Phosphate Buffered Saline 用于样品制备
含 90ml 磷酸盐缓冲液均质袋 Phosphate Buffered Saline 用于样品制备
含 200ml 生理盐水均质袋 Physiological Saline 用于样品稀释处理
含 225ml 生理盐水均质袋 Physiological Saline 用于样品稀释处理
含 225ml 缓冲蛋白胨水(BPW)均质袋 Buffered Peptone Water 用于沙门氏菌、阪崎杆菌制样和前增菌培养
含 900ml 缓冲蛋白胨水(BPW)均质袋 Buffered Peptone Water 用于阪崎杆菌的定量
含 90ml 缓冲蛋白胨水(BPW)均质袋 Buffered Peptone Water 用于阪崎杆菌的定量
含 100ml 缓冲蛋白胨水(BPW)均质袋 Buffered Peptone Water 用于阪崎杆菌的定量
含 225ml 3%氯化钠碱性蛋白胨水均质袋 3% NaCl Alkaline Peptone Water 用于副溶血性弧菌的前增菌培养
含 225ml mEC+n 肉汤均质袋 mEC+n Broth 用于大肠杆菌 O157 菌前增菌培养
新生霉素 Novobiocin 每支添加于 225ml HBJ004 中
含 225ml LB1 肉汤均质袋 LB1 Broth 用于李斯特氏菌制样和前增菌培养
萘啶酮酸 Nalidixic Acid 每支添加于 225ml HBJ005 中制成LB1 肉汤
吖啶黄素 Acridine Flavin 每支添加于 225ml HBJ005 中制成LB1 肉汤
含 225ml GN 增菌液均质袋 GN Enrichment Broth 用于志贺氏菌前增菌培养
含 225ml 志贺氏菌増菌肉汤均质袋 Shigella Enrichment Broth 用于志贺氏菌前增菌培养
含 225ml 7.5%氯化钠肉汤均质袋 7.5% NaCl Broth 用于金葡菌前增菌培养
含 50ml 7.5%氯化钠肉汤均质袋 7.5% NaCl Broth
含 225ml 10%氯化钠胰酪胨大豆肉汤均质袋 10% NaCl Trypticase Soy Broth
含 225ml 布氏肉汤均质袋 Brucella Broth 用于空肠弯曲菌的前增菌
布氏肉汤添加剂(2ml/支) Brucella Broth Supplement 添加于 HBJ014 中
含 225ml Bolton 肉汤均质袋 Bolton Broth 用于空肠弯曲菌的增菌培养
含 100ml Bolton 肉汤均质袋 Bolton Broth 用于空肠弯曲菌的增菌培养
Bolton 肉汤添加剂 Bolton Broth Supplement 添加于 HBJ023-1 和 HBJ007 中
含225ml 胰酪胨大豆多粘菌素肉汤均质袋 Trypticase Soy Polymyxin Broth 用于蜡样芽孢杆菌的前增菌培养
多粘菌素 B Polymyxin B 每支添加于 225ml HBJ016 中
含 225ml 改良胰蛋白胨大豆肉汤均质贷 用于检测 ß-溶血性链球菌的样品增菌(GB 标准)
萘啶酮酸 2.25mg 每支添加于 225mlHBJ4114-20 中,
多粘菌素 B 2.25mg 每支添加于 225mlHBJ4114-20 中,
含 225ml FB1 增菌液均质袋 FB1 Broth 用于李氏菌前增菌培养
FB1(Half‐Fraser)添加剂(A、B) FB1 additive(A、B) 每支添加到 225ml HBJ006 中
0.85%无菌生理盐水 0.85% Sterile Saline 用于样品稀释处理
磷酸盐缓冲液 (PBS pH7.2) Phosphate Buffered Saline 用于菌落总数,大肠菌群,金葡菌,大肠杆菌样品制备
LST 发酵管(含小倒管) LST 用于大肠菌群、大肠杆菌的测定
月桂基硫酸盐胰蛋白胨肉汤 LST 管(双料,含小倒管) Lauryl Sulfate Tryptose Broth 用于大肠菌群、大肠杆菌的测定
EC 肉汤(含小倒管) EC Broth 用于粪大肠菌群、大肠杆菌的测定
煌绿乳糖胆盐肉汤 BGLB(含小倒管) Brilliant Green Lactose Bile Broth 用于大肠菌群、大肠杆菌的测定
双料乳糖胆盐发酵培养基管(含小倒管) Double Lactose Bile Ferment Broth 用于大肠菌群的测定
单料乳糖胆盐发酵培养基管(含小倒管) Lactose Bile Ferment Broth 用于大肠菌群、大肠杆菌的测定
乳糖蛋白胨培养液(含小倒管) Lactose Peptone Broth 用于大肠菌群、大肠杆菌的测定
双料乳糖蛋白胨培养液(含小倒管) Double Lactose Peptone Broth 用于大肠菌群、大肠杆菌的测定
缓冲蛋白胨水(BPW) Buffer peptone water(BPW) 用于沙门氏菌和阪崎杆菌的增菌
四硫磺酸盐煌绿增菌液(TTB 肉汤) TTB Broth 用于沙门氏菌选择性增菌培养
盐胱氨酸增菌液(SC) Selenite Cystine Broth 用于沙门氏菌选择性增菌培养
GN 增菌液 GN Enrichment Broth 主要用于志贺氏菌增菌培养,亦可用于沙门氏菌增菌培养
RV 肉汤 RV Broth 用于沙门氏菌选择性增菌培养
SBG 增菌液 SBG Enrichment Broth 用于沙门氏菌的增菌培养
改良月桂基硫酸盐胰蛋白胨肉汤‐万古霉素 Modified Lauryl Sulfate Tryptose Broth‐ VancoMycin Medium 用于阪崎杆菌选择性增菌培养
李氏菌增菌肉汤(LB1) Listeria Enrichment Broth Base 用于李氏菌增菌培养
李氏菌增菌肉汤(LB2) Listeria Enrichment Broth Base 用于李氏菌二步增菌
改良 EC(mEC+n)肉汤 Modified EC Enrichment Broth 用于 O157 菌选择性增菌
LST‐MUG LST‐MUG 用于 O157 菌的荧光试验
改良磷酸盐缓冲液(PBS) Phosphate Buffered Saline 用于小肠结肠炎耶尔森氏菌增菌培养
3%氯化钠碱性蛋白胨水 3%Sodium Chloride Peptone Water 副弧菌的选择性增菌
4%氯化钠碱性蛋白胨水 4%Sodium Chloride Peptone Water 副弧菌的选择性增菌
10%氯化钠胰酪胨大豆肉汤 10% NaCl Trypticase Soy Broth 用于金黄色葡萄球菌的 MPN 测定及增菌培养
11%氯化钠胰酪胨大豆肉汤 11% NaCl Trypticase Soy Broth 用于金黄色葡萄球菌的 MPN 测定及增菌培养
胰酪胨大豆多粘菌素肉汤 Trypticase‐Soy‐Polymyxin Broth Base 用于蜡样芽孢杆菌的 MPN 值测定
三糖铁管 TSI 用于肠杆菌科细菌的生化反应筛选
3%氯化钠三糖铁管 用于副溶血性弧菌的生化反应筛选
改良克氏三糖铁管 用于小肠结肠炎耶尔森氏菌的生化
MIU 培养基 MIU Medium 用于细菌的复合生化试验
金氏 B 培养基管 用于铜绿假单菌产荧光色素试验
MUG 快速鉴定大肠试剂 MUG 用于快速鉴定大肠杆菌
EC‐MUG 管 用于生活饮用水及其水源水中的大肠埃希氏菌的检测
氯、碘中和剂管 Chlorine, Iodine Neutralizer 用于消毒剂的中和
醛类中和剂管 Aldehyde Neutralizer 用于消毒剂的中和
醇类中和剂管 Alcohol Neutralizer 用于消毒剂的中和
SCDLP 液体培养基管 用于化妆品的样品制备
溴甲酚紫葡萄糖蛋白胨水管 用于压力蒸气消毒过程监测指示菌(嗜热脂肪杆菌芽孢)的培养及消毒效果测定
瓷珠菌种保存管 Strain Store Medium 用于菌种保存(瓷珠法),
液体菌种保存管 用于菌种的保存
军团菌菌种保存管 专用于军团菌的保存
Cary‐Blair 氏运送培养基 Cary‐Blair Transport Medium 用于微生物样品的采集、运送和保存,特别是空肠弯曲菌、霍乱弧菌、副溶血性弧菌、沙门氏菌和志贺氏菌等
Cary‐Blair 氏运送管(液体) Cary‐Blair Transport Medium 用于微生物样品的采集、运送和保存,特别是空肠弯曲菌、霍乱弧菌、副溶血性弧菌、沙门氏菌和志贺氏菌等
Cary‐Blair 氏运送管(40ml) Cary‐Blair Transport Medium 可同时保存 5 支采样拭子标本
Amies 运送培养基 Amies Transport Medium 用于标本采集、存放、传递。广泛用于口腔科、皮肤科、妇科、泌尿科等标本的取样
Amies 运送培养基(含活性炭) Amies Transport Medium 用于标本采集、存放、传递。广泛用于口腔科、皮肤科、妇科、泌尿科等标本的取样
Stuart 运送培养基 Stuart Transport Medium 用于标本采集、存放、传递。广泛用于口腔科、皮肤科、妇科、泌尿科等标本的取样
Stuart 运送培养基(液体) Stuart Transport Medium 主要用于咽喉、伤口等标本运送特别是奈瑟氏菌属、肺炎球菌、沙门氏菌属等标本的采取和运输
Stuart 运送培养基(含活性碳) Stuart Transport Medium 主要用于咽喉、伤口等标本运送特别是奈瑟氏菌属、肺炎球菌、沙门氏菌属等标本的采取和运输
无菌病毒运输液 (VTM) VTM Broth 用于甲流病毒标本运送
MEM 维持液 MEM maintenance of fluid 主要用于用于手足口病样品的运输
无菌采样袋(45cm*55cm) Sterile Homogeneous Bag 用于样品的采样(容量 3.5L)
无菌采样袋/均质袋(32cm*20cm)(带压条) Sterile Homogeneous Bag 用于样品的采样或均质
无菌均质袋(32cm*20cm)(不带压条) Sterile Homogeneous Bag 用于样品的均质
无菌采样袋(12cm*18cm)(带压条) Aseptic Sampling Bag 用于 50g 内固体样品的采样
无菌采样袋(带铁丝)(11.4cm*22.9cm) 用于固体或液体样品的采样
水样采集袋 Water Aseptic Sampling Bag 用于 1L 内水质的无菌采样,500ml刻度线
水样采集袋(含硫代硫酸钠) Water Aseptic Sampling Bag 用于需要中和硫代硫酸钠的生活饮用水、游泳池等水的无菌采样(含0.4mg 硫代硫酸钠),500ml 刻度线
2.5L包 每只用于 2.5L
2.5L气袋 每只用于 2.5L
氧气指示剂 用于厌氧系统中氧气指示
350ml 厌氧产气包 每只用于 350ml
350ml 厌氧培养袋 可装 2-4 个培养皿
2.5L圆底立式厌氧培养袋 可装 12 个培养皿
LB 肉汤(Miller) LB Broth(Miller) 用于基因工程菌大肠埃希氏菌培养
LB 肉汤(Lennox) LB Broth(Lennox) 用于基因工程菌大肠埃希氏菌培养
LB 营养琼脂 LB Agar 用于基因工程菌大肠埃希氏菌培养
SOB 培养基 SOB Medium 用于基因工程菌大肠埃希氏菌培养
SOC 培养基 用于基因工程菌大肠埃希氏菌培养
2×YT 肉汤 2×YT Broth 用于基因工程菌大肠埃希氏菌培养
TB 培养基 Terrific Broth 用于基因工程菌大肠埃希氏菌培养
SB 培养基 Super Broth 用于大肠埃希菌产纤毛抗体培养,属细菌疫苗培养基
改良 mincal 肉汤 用于大肠埃希菌产纤毛抗体培养,属细菌疫苗培养基
HB‐PE 自诱导培养基 HB‐PET Auto Express Medium 用于基因工程菌大肠埃希氏菌诱导蛋白
YNB 培养基 YNB Medium 用于基因工程中酵母菌的发酵培养
蛋白高效表达培养基 用于基因工程大肠杆菌高效表达外源蛋
磷酸盐缓冲液(PH7.2) PBS Broth 用于样品的稀释、制备等同生理盐水
营养琼脂 (NA) Nutrient Agar 细菌计数、不含糖,可作血琼脂基础和传代用
平板计数琼脂(PCA) Plate Count Agar 国际标准平板计数琼脂,含糖,用于细菌总数的测定
嗜冷菌计数琼脂(乳平板计数琼脂) Psychrophilic Bacteria Count Agar 用于奶制品中嗜冷微生物的菌落总数测定
MPC 琼脂培养基(改良平板计数琼脂) MPC Agar Medium 用于奶制品中菌落总数测定(阻抗法)
营养肉汤 (NB) Nutrient Broth 一般细菌培养、转种、复壮、增菌等
胰蛋白胨大豆琼脂(TSA) TSA Agar 一种通用培养基,用于各种微生物的培养,也用于奶粉中阪崎杆菌的纯化培养和产黄色素试验
TTC 营养琼脂 TTC Nutrient Agar 用于细菌总数测定
2216E 琼脂 2216E Agar 用于海生细菌的培养和计数
2216E 液体培养基 2216E Broth 用于海生细菌的培养
标准 I 号营养琼脂 Standard I Nutrient Agar 标准细菌计数、含糖
酵母粉琼脂 Yeast Extract Agar 用于水中细菌、酵母菌、霉菌菌落总数的检测(ISO9038 标准)
胰胨大豆胨固绿琼脂 Tryptic Soy Fast Green Agar 用于滤膜法细菌总数的测定和分离培养(NEOGEN 方法)
m‐TGE 肉汤 m‐TGE Broth 用于奶制品中滤膜法细菌总数计数
水平板计数琼脂培养基 Water Plate Count Agar 用于饲料中细菌总数测定
R2A 琼脂 R2A Agar 用于饮用水中细菌总数测定(USP、EP方法)
接触皿培养基 Min Media Contacts 用于生产环境的菌落总数检测
CVT 琼脂 CVT Agar 用于乳制品中嗜冷菌的计数培养三天即可
WL 营养琼脂 WL Nutrient Agar 用于啤酒和发酵产品中酵母菌和细菌的计数
LG 培养基 LG medium 用于霉菌、酵母菌、耐热霉菌及细菌总数检测,以及 PET 瓶、无菌罐装生产线
孟加拉红培养基 (虎红琼脂) Rose Bengal Medium 用于食品中霉菌及酵母菌总数测定
马铃薯葡萄糖琼脂 (PDA) Potato Dextrose Agar 用于霉菌、酵母菌计数
马铃薯葡萄糖琼脂(含氯霉素) Potato Dextrose Agar(Chloramphenicol) 用于霉菌、酵母菌计数
30%葡萄糖溶液(PH6.5±0.5) 30% Dextrose Broth 用于蜂蜜样品的处理和稀释
氯硝胺 18%甘油(DG18)琼脂 DG18 Agar 用于蜂蜜中嗜渗酵母计数(GB14963-2011)
氯霉素溶液(20mg) Chloramphenicol Solution 每支添加于 200ml 的基础液中
察氏琼脂 Czapek Dox Agar 用于青霉、曲霉鉴定及保存菌种用(GB标准)
产毒培养基 Toxin‐Producing Medium 用于青霉、曲霉的产毒培养
马铃薯葡萄糖水 Potato Dextrose Medium 用于椰毒假单胞酵米面亚种和真菌的增菌培养(GB 标准)
马铃薯葡萄糖半固体琼脂 Potato Dextrose Semi‐solid Agar 用于椰毒假单胞酵米面亚种的产毒培养(GB 标准)
高盐察氏琼脂 Salt Czapek Dox Agar 用于饲料中霉菌的计数(GB 标准)
沙氏琼脂培养基 Sabouraud’s Agar 用于真菌检测 (GB 标准)
霉菌培养基(含琼脂和氯霉素) Fungal Medium 用于霉菌的分离培养
土霉素麦芽提取物琼脂培养基 Oxytetracycline Malt ExtractAgar Medium 用于真菌的分离培养
玉米粉琼脂 Corn Meat Medium 用于真菌培养及鉴定
TTC‐沙堡罗培养基 TTC‐Sha Baoluo Medium 用于分离真菌、酵母菌等
酵母粉葡萄糖氯霉素琼脂(YDC) Yeast Extract DextroseChloramphenicol Agar 用于食品中霉菌及酵母菌总数测定
酵母浸出物葡萄糖土霉素琼脂培养基 Yeast Extract GlucoseOxytetracycline Agar 用于乳及乳品霉菌、酵母菌计数(SNT 2552.3)
Candida Elective 琼脂 Candida Elective Agar to Nickerson 用于食品中念珠菌及酵母菌总数测定
DTM 培养基 DTM Medium 用于食品中真菌的培养
DRBC 琼脂 DRBC Agar 用于食品中霉菌及酵母菌分离培养
WORT 琼脂 Wort Agar 用于真菌,特别是酵母菌的计数
WORT 肉汤 Wort Broth 用于真菌,特别是酵母菌的培养
YGC 琼脂 YGC Agar 用于奶和奶制品中霉菌及酵母菌分离培
改良绿色酵母菌和真菌肉汤 m‐GREEN YEAST and FUNGI BROTH 用于啤酒、饮料等滤膜法真菌及酵母菌
Littman 琼脂 Littman Agar 用于真菌的分离培养
DG‐18 琼脂 DG‐18 Agar 用于食品中霉菌和酵母菌分离培养
YM 琼脂 YM Agar 用于霉菌、酵母菌及耐酸菌的分离培养
YM 培养基 YM Medium 用于霉菌和酵母菌的增菌培养
YM11 琼脂 YM11 Agar 滤膜法用于霉菌、酵母菌的分离培养
OGY 琼脂 OGY Agar 用于霉菌和酵母菌分离培养和计数
改良沙氏琼脂培养基 Sabouraud’s Agar,Modified 用于真菌检测
沙氏 BHI 琼脂 Sabouraud BHI Agar 用于真菌检测
营养盐琼脂 Nutrient Agar 用于纺织中检验材料耐真菌、霉菌的效能
1%吐温 80‐玉米琼脂培养基 1%Tween80‐Corn Meat Agar Mediun 用于白色念珠菌产芽管试验
麦芽浸膏琼脂(MEA) Malt Extract Broth 用于霉菌和酵母菌的分离培养和计数
麦芽浸膏汤(MEB) Malt Extract Broth 用于霉菌和酵母菌的培养
麦芽汁琼脂 Wort Agar 用于霉菌和酵母菌的培养
BIGGY 琼脂BIGGY agar 用于念珠菌的分离培养和计数
皮肤癣菌鉴别琼脂(DTM) DTM Agar 用于皮肤癣菌鉴别培养
WLN 培养基 WLN Medium 用于酿造和工业发酵过程中细菌、酵母菌和霉菌培养
改良察氏液体培养基 Modified Czapek Liquid Medium 用于霉菌的增菌培养基(GB 标准)
面包酵母标准培养基 Baker Yeast Standard Medium 用于面包酵母计数培养
野生酵母培养基 Wild Yeast Medium 用于野生酵母计数培养
月桂基硫酸盐胰蛋白胨肉汤(LST) Lauryl Sulfate Tryptose Broth 用于 MPN 法大肠菌群,大肠埃希氏菌的测定(GB、SN 标准)
双料月桂基硫酸盐胰蛋白胨肉汤(LST) Lauryl Sulfate Tryptose Broth 用于大肠菌群, 大肠埃希氏菌的测定(GB、SN 标准)
煌绿乳糖胆盐肉汤 (BGLB) Brilliant Green Lactose Bile Broth 用于大肠菌群、大肠埃希氏菌的测定(GB、SN 标准)
EC 肉汤 E.Coli Broth 用于粪大肠菌群、大肠埃希氏菌的测定(GB、SN 标准)
伊红美蓝琼脂 (EMB) Eosin‐Methylene Blue Agar 弱选择性培养基、用于分离肠道致病菌,特别是大肠杆菌(GB、SN 标准)
乳糖胆盐发酵培养基 Lactose Bile Broth 用于大肠菌群,粪大肠菌群,大肠埃希氏菌的测定(GB 标准)
乳糖复发酵培养基 Lactose Broth 用于大肠菌群,粪大肠菌群, 大肠埃希氏菌的测定(GB 标准)
去氧胆酸盐琼脂(DC)&nbs
风险提示:丁香通仅作为第三方平台,为商家信息发布提供平台空间。用户咨询产品时请注意保护个人信息及财产安全,合理判断,谨慎选购商品,商家和用户对交易行为负责。对于医疗器械类产品,请先查证核实企业经营资质和医疗器械产品注册证情况。
技术资料暂无技术资料 索取技术资料
BIGGY 琼脂BIGGY agar
询价








